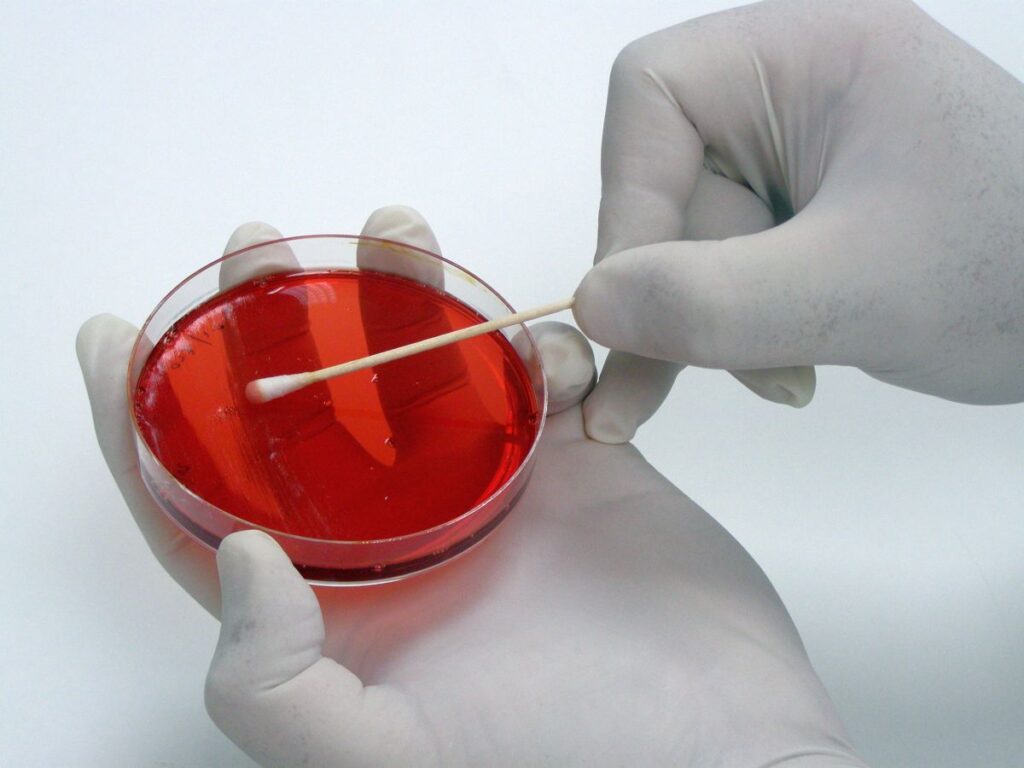

ESTABLISHMENT
CHEMICOTECHNIKI WAS FOUNDED IN AUGUST 1986
Aphrodite Lagouvardou-Spantidaki, Chemist laid the foundations for the establishment of CHEMICOTECHNIKI, which has been active in the field of Analytical Laboratories until today.
The founding date is significant because on the same day the company was established, Maria Spantidaki was also born, who is now a co-owner of the company and represents both the new generation and its vitality.
Since 2012, the business has relocated to new privately owned facilities, covering 600 square meters, in an independent building at the entrance of Rethymno.

The CHEMICOTECHNIKI Laboratories are among the first laboratories in Greece to operate for many decades under the international quality systems ISO 17025 and among the first to be accredited by ΕΣΥΔ (Certificate Number 46/05). Additionally, they are members of the international cooperation for laboratory accreditation (ILAC).
The diverse team of laboratories consists of specialized scientists from various disciplines: Chemists, Chemical Engineers, Biologists, Agronomists, and Food Technologists.
Throughout all these years, the name CHEMICOTECHNIKI has been associated with excellent, high-quality laboratory analyses and technical consulting services.
Our valuable experience accumulated over thirty years in various fields, coupled with our expertise in laboratory services, provide us with a significant competitive advantage in the market.
Therefore, our products and solutions are designed to precisely meet the needs of our clients and the market
OUR COMPANY
WHY CHEMICOTECHNIKI

Sampling
Performed with appropriate equipment in Crete and the Dodecanese Islands by specialized personnel.

Crete
The largest Accreditation Field in Crete

Greece
Among the largest Accreditation Fields in Greece

Consulting
Excellent Technical Support
MANAGEMENT
LABORATORY MANAGEMENT
CHEMICOTECHNIKI has a highly qualified team of scientists with expertise and experience in water quality control, environmental monitoring, food, and beverage analysis.
At the laboratories, the scientific staff includes Chemical Engineers, Chemists, Biologists, Agronomists, & Food Technologists.
The company’s management is conducted by its two members: Aphrodite Lagouvardou-Spantidaki and Maria Spantidaki. Both members of the management team are dedicated to continuous investment in time and resources, aiming to better serve the company’s clients.
MANAGEMENT
Aphrodite Lagouvardou-Spantidaki
Chemical Engineer, Aristotle University of Thessaloniki
Maria I. Spantidaki
Chemist, MSc, Aristotle University of Thessaloniki
ANALYTICAL LABORATORIES
OUR FACILITIES
CHEMICOTECHNIKI
EQUIPMENT & DEPARTMENTS
Sample registration and reception department
All samples, once they arrive at the laboratory, whether from sampling conducted by the company’s trained personnel or directly from the client, are received, the reception forms are completed, they are registered, and they receive a unique laboratory code number for sample traceability
To ensure the quality of services and to provide faster, easier, and more effective customer service, CHEMIKOTECHNIKI has implemented the LIMS–LAB @LINK laboratory data management program, which was developed over six years in collaboration with an application development company..
EQUIPMENT OF THE CHEMICAL LABORATORY DEPARTMENT
Equipment of the microbiology laboratory department
Equipment of the molecular biology department
Equipment of the sensory testing department for olive oil
The sensory evaluation of olive oils is conducted in specially designed testing booths where absence of odors and noise is ensured. Each booth is equipped with a heating device where the special testing glasses with the samples under evaluation are placed. The testing glass is dark blue in color to prevent the tester from being influenced by the color of the olive oil, which is not a quality criterion.
Additionally, each booth is equipped with lighting and a disposal vessel for the samples under evaluation. The laboratories of CHEMIKOTECHNIKI are accredited with an organoleptic panel from the Hellenic Food Authority and recognized by the International Olive Council.
Ms. Maria Spantidaki, a Chemist and Technical Director of the Laboratories, heads the Sensory Testing Laboratory.
Equipment of the sampling department
The laboratory is equipped with 5 professional vehicles.
A critical aspect for obtaining reliable results is proper sampling and the swift transportation of the sample under suitable conditions to the laboratory.
Even the most accurate and detailed analysis will yield incorrect results if the sample is not taken correctly or if its transportation did not occur under the required conditions and in a timely manner.
Additionally, it includes precision instruments for sample collection and field parameter measurement, such as:
Accounting Department
The laboratory has an internal accountant who is responsible for:
- Purchase invoices
- Invoices and expense receipts
- Payments
- Import expense invoices
- Bank transactions
- Suppliers
JOB OPPORTUNITIES
CAREER OPPORTUNITY AT CHEMICOTECHNIKI IN RETHYMNO
Working at Chemical Laboratories means participation in a passionate scientific team that is constantly evolving and provides superior customer service.
Please send your resume, which will remain in our files for potential future collaboration, in case there is a job opening at our company.